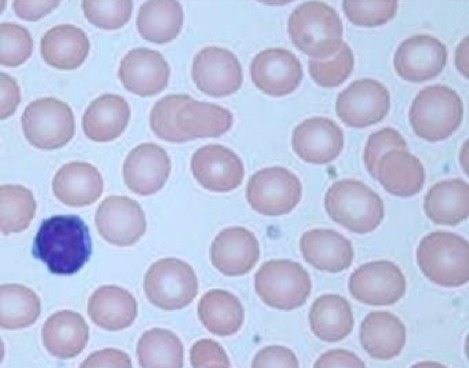

Sign up for FlowVella
Sign up with FacebookAlready have an account? Sign in now
By registering you are agreeing to our
Terms of Service
Loading Flow


Normal RBC
These cells are round like disks, are about 7m in diameter, and have a "pallor zone"(less hemoglobin). On the left they have a band of neutrophil and on the right a segmented neutrophil. These cells don't have any disorders.d